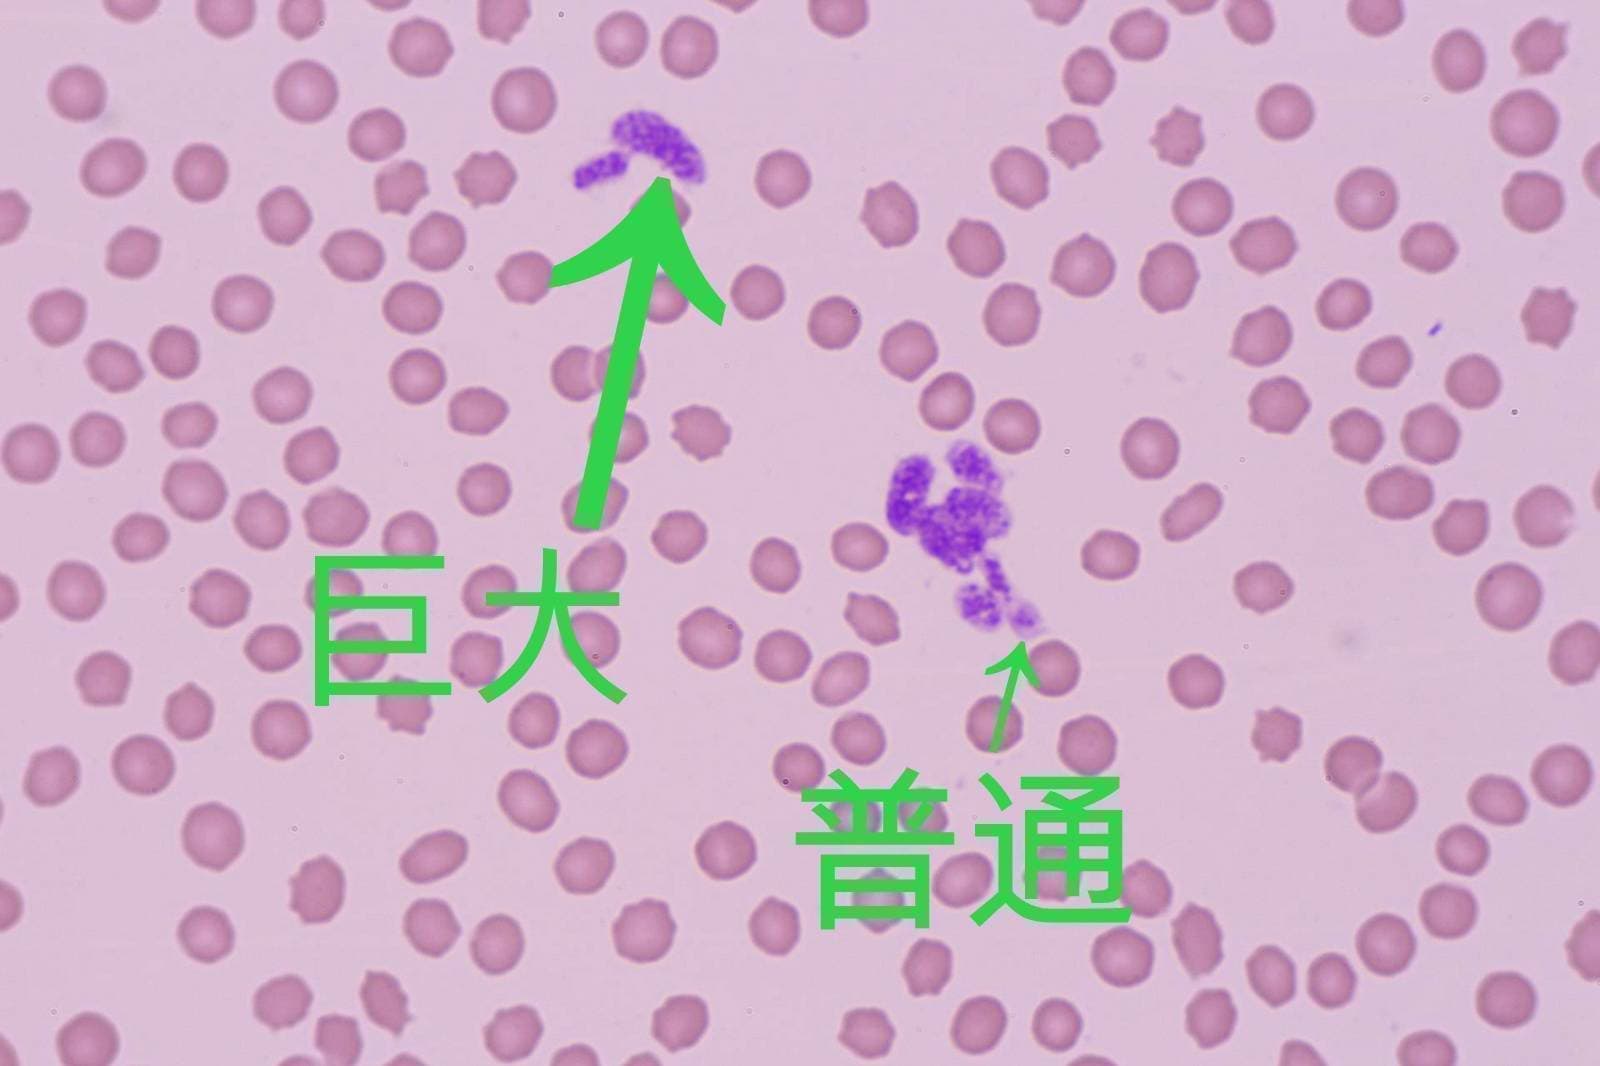
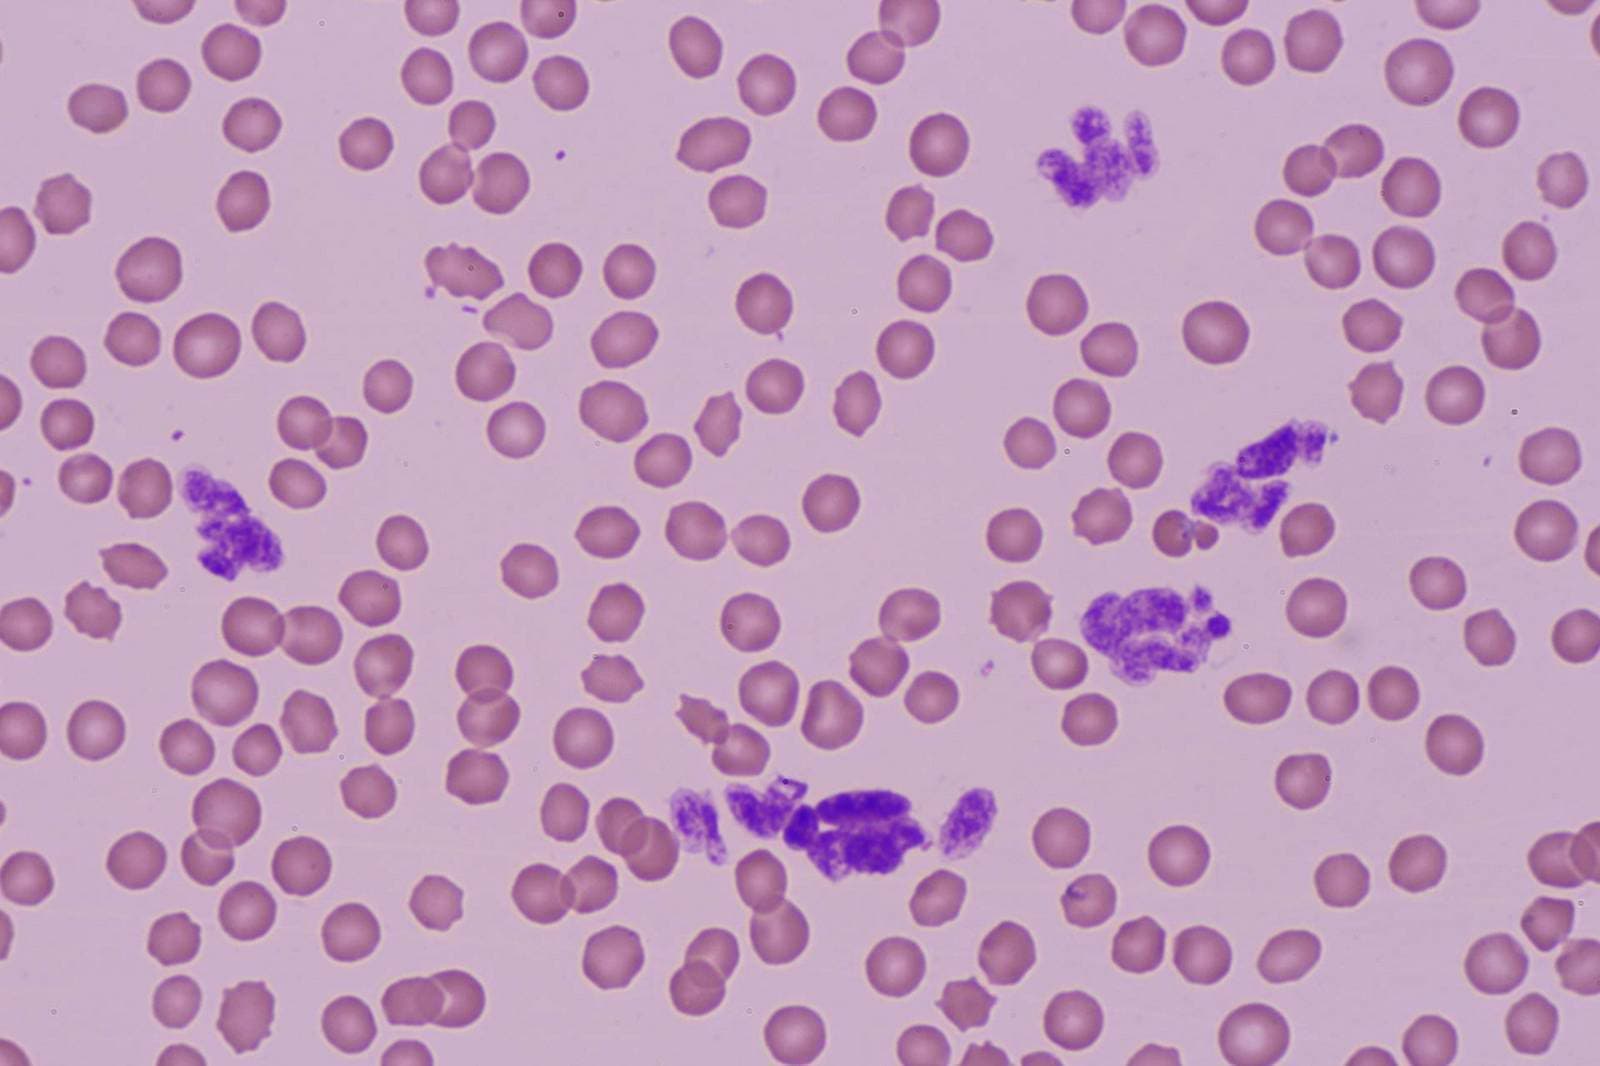
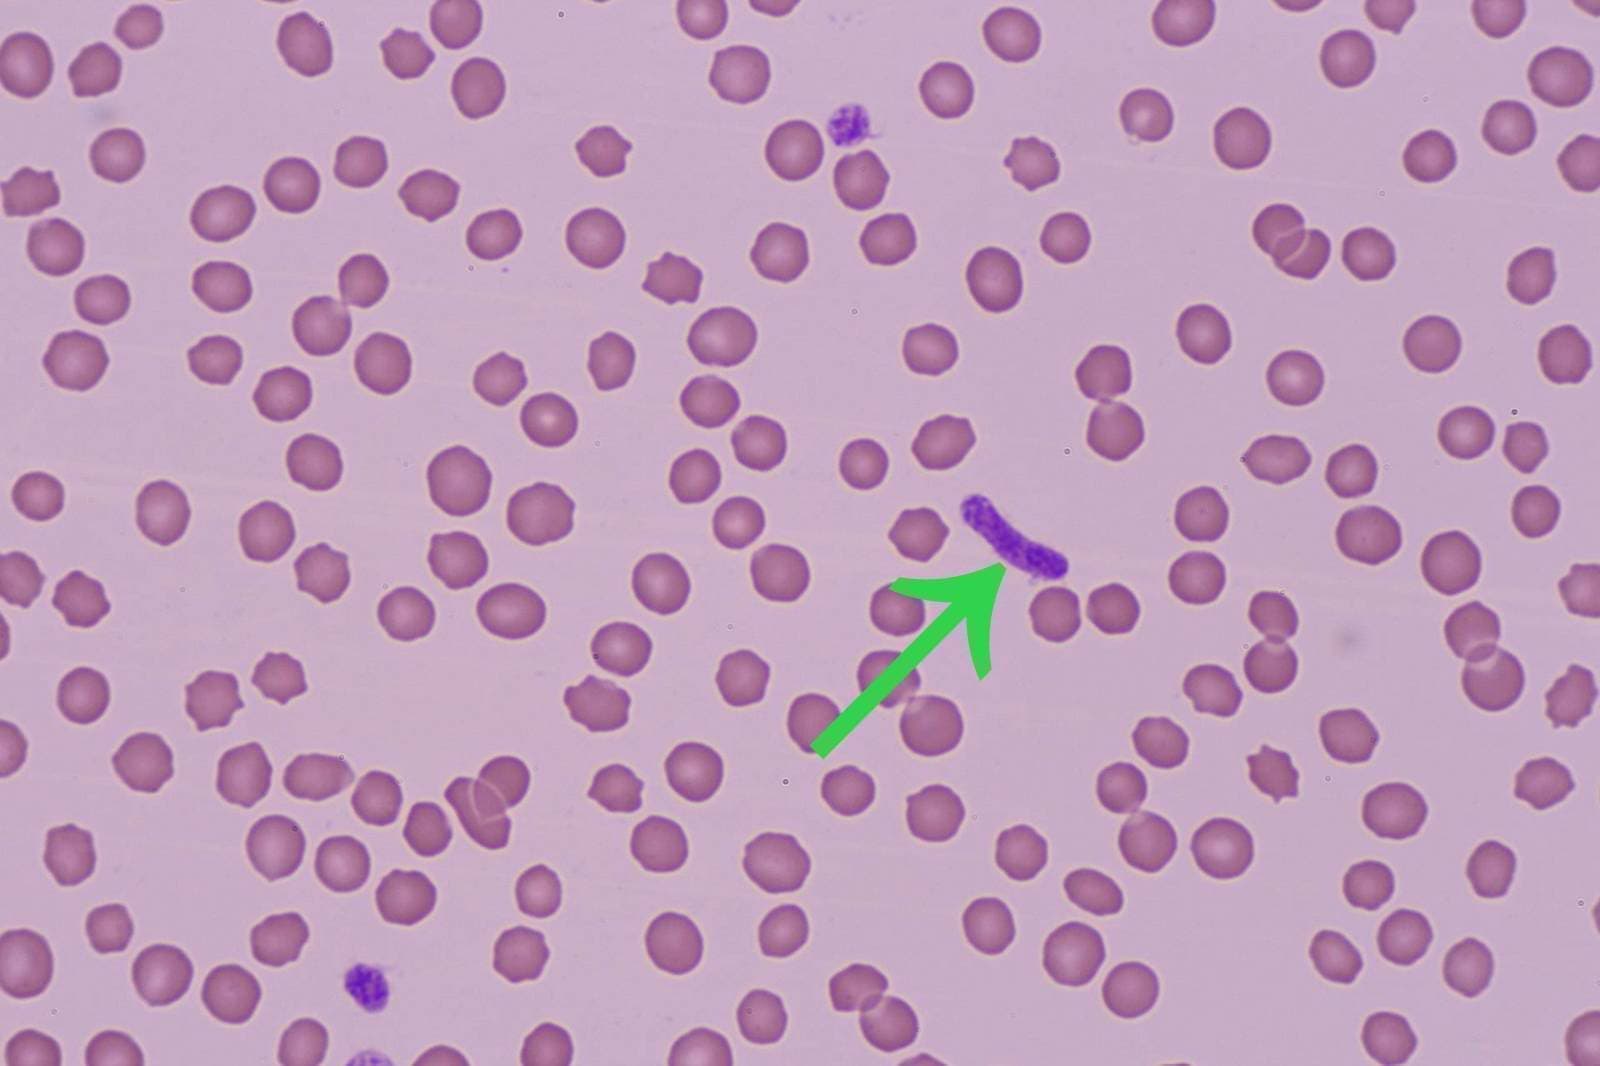

治療実績
WORKS
巨大血小板 |
---|
血液の顕微鏡写真
矢印のものが血小板です。血小板には様々な働きがあり、重要な血液細胞です。いろいろな形に変わります。大きなサイズのものを巨大血小板と呼びます。
血液の顕微鏡写真
これは猫のものですが、猫は巨大でも問題ないと判断することが多いです。
血液の顕微鏡写真
ちょっと見慣れない形のものもあります。当院の血液検査では血小板の形までよく観察し、診断精度の向上に役立てます。
受付時間
受付時間 | 月 | 火 | 水 | 木 | 金 | 土 | 日祝 |
---|---|---|---|---|---|---|---|
9:50-12:45 | ○ | ○ | 休 | ○ | ○ | ○ | ○ |
15:50-18:45 | ○ | ○ | 休 | ○ | ○ | ○ | ○ |
水曜休診
夏季休業なし
12月30日から1月3日休診